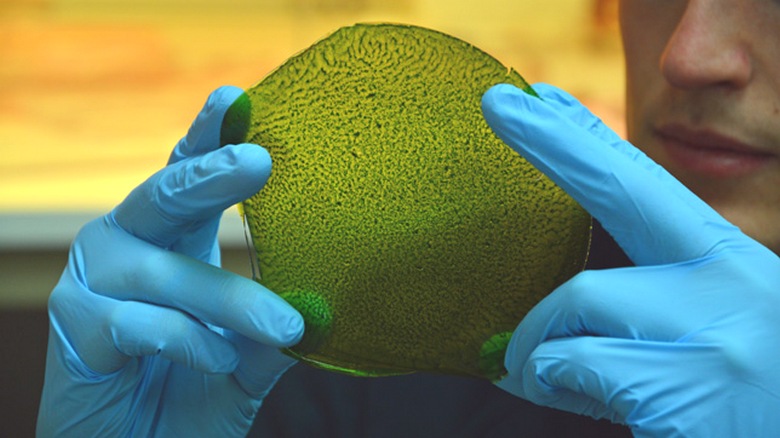

снимка от открити източници
снимка от открити източници
Идеята за създаване на изкуствени листа, които биха могли рециклиране на излишния въглероден диоксид се появи в миналото век, но тя стана особено актуална в наше време, когато планетата буквално се задушава от парникови газове и гори това само намалява.
За първи път успехът на създаването на изкуствен лист беше тръбен през 2014 г. годината, когато студент по английски език Джулиан Мелкиори демонстрира научния свят неговото изобретение – суспензия от хлоропласти, която той изолирани от листата на растението и поставени в вещество от фиброин коприна.
снимка от открити източници
снимка от открити източници
Имаше и други подобни изобретения, но всички те съгрешиха от който демонстрира фотосинтеза на лабораторно ниво и за разрешаване бяха необходими проблеми с парниковите газове в световен мащаб изкуствени листове на големи площи, с условието, че те самите те и в големи количества изтеглиха въглероден диоксид въздух.
И тогава учени от Университета на Илинойс в Чикаго сякаш излизат близо до решаването на този проблем. Според Минеш Синг, един от съавторите на това изобретение е поставен техният изкуствен лист във водна капсула от полупропусклива мембрана, способна да абсорбира CO2 способен да преобразува парникови газове в кислород и въглероден оксид газ. И ако първата може просто да бъде изпратена обратно във въздуха, тогава вторият е отличен изходен материал за производство на синтетичен гориво. Изкуствен лист, площ само на една трета от площада метри, способни да произвеждат до половин тон CO на ден.
 снимка от открити източници
снимка от открити източници
Сингх в съобщение за печата, публикувано на сайта Институт, уверява, че техните изкуствени листове, площ от 500 квадратни метра могат да понижат нивата на въглероден диоксид в въздушно пространство в рамките на сто метра с 10 процента на човек дневни часове. Той е многократно по-ефективен от естествения зеленина. Освен това изкуствените листа не изискват никакъв комплекс технологични и материални разходи – всичко това е евтино, лесно и доста ефективен. Учените от UIC уверено заявяват това тяхното изобретение трябва да играе значителна роля за намаляване парникови газове в земната атмосфера без увеличаване на площта под зелени пространства.
Можете да прочетете повече за всичко това в научното списание. Устойчива химия и инженерство, включително ентусиазирани рецензии на много видни учени от света, които оцениха постижения изследователи от Чикаго.






